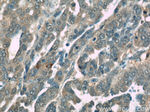
TIPE2 Antibody in Immunohistochemistry (Paraffin) (IHC (P))

Search
Proteintech
TIPE2 Polyclonal Antibody
{{$productOrderCtrl.translations['antibody.pdp.commerceCard.promotion.promotions']}}
{{$productOrderCtrl.translations['antibody.pdp.commerceCard.promotion.viewpromo']}}
{{$productOrderCtrl.translations['antibody.pdp.commerceCard.promotion.promocode']}}: {{promo.promoCode}} {{promo.promoTitle}} {{promo.promoDescription}}. {{$productOrderCtrl.translations['antibody.pdp.commerceCard.promotion.learnmore']}}
产品信息
15940-1-AP
种属反应
已发表种属
宿主/亚型
分类
类型
抗原
偶联物
形式
浓度
规格
纯化类型
保存液
内含物
保存条件
运输条件
产品详细信息
Immunogen sequence: MESFSSKSL ALQAEKKLLS KMAGRSVAHL FIDETSSEVL DELYRVSKEY THSRPQAQRV IKDLIKVAIK VAVLHRNGSF GPSELALATR FRQKLRQGAM TALSFGEVDF TFEAAVLAGL LTECRDVLLE LVEHHLTPKS HGRIRHVFDH FSDPGLLTAL YGPDFTQHLG KICDGLRKLL DEGKL (1-184 aa encoded by BC063014)
靶标信息
TNFAIP8L2 - Tumor necrosis factor alpha-induced protein 8-like protein 2 (also known as TIPE2) acts as a negative regulator of innate and adaptive immunity by maintaining immune homeostasis. It is a negative regulator of Toll-like receptor and T-cell receptor functions. TIPE2 prevents hyperresponsiveness of the immune system and maintains immune homeostasis. It inhibits JUN/AP1 and NF-kappa-B activation. TIPE2 also promotes Fas-induced apoptosis.
仅用于科研。不用于诊断过程。未经明确授权不得转售。
生物信息学
蛋白别名: FLJ23467; Inf20; inflammation factor 20; Inflammation factor protein 20; TIPE2; TNF alpha-induced protein 8-like protein 2; TNFAIP8-like protein 2; TP8L2; Tumor necrosis factor alpha-induced protein 8-like protein 2; tumor necrosis factor, alpha induced protein 8 like 2; tumor necrosis factor, alpha-induced protein 8-like protein 2; unnamed protein product
基因别名: 1810019A08Rik; AW610835; RGD1310519; TIPE2; TNFAIP8L2
UniProt ID: (Human) Q6I9Y0, (Mouse) Q9D8Y7, (Rat) Q6AYJ8
Entrez Gene ID: (Human) 79626, (Mouse) 69769, (Rat) 310663